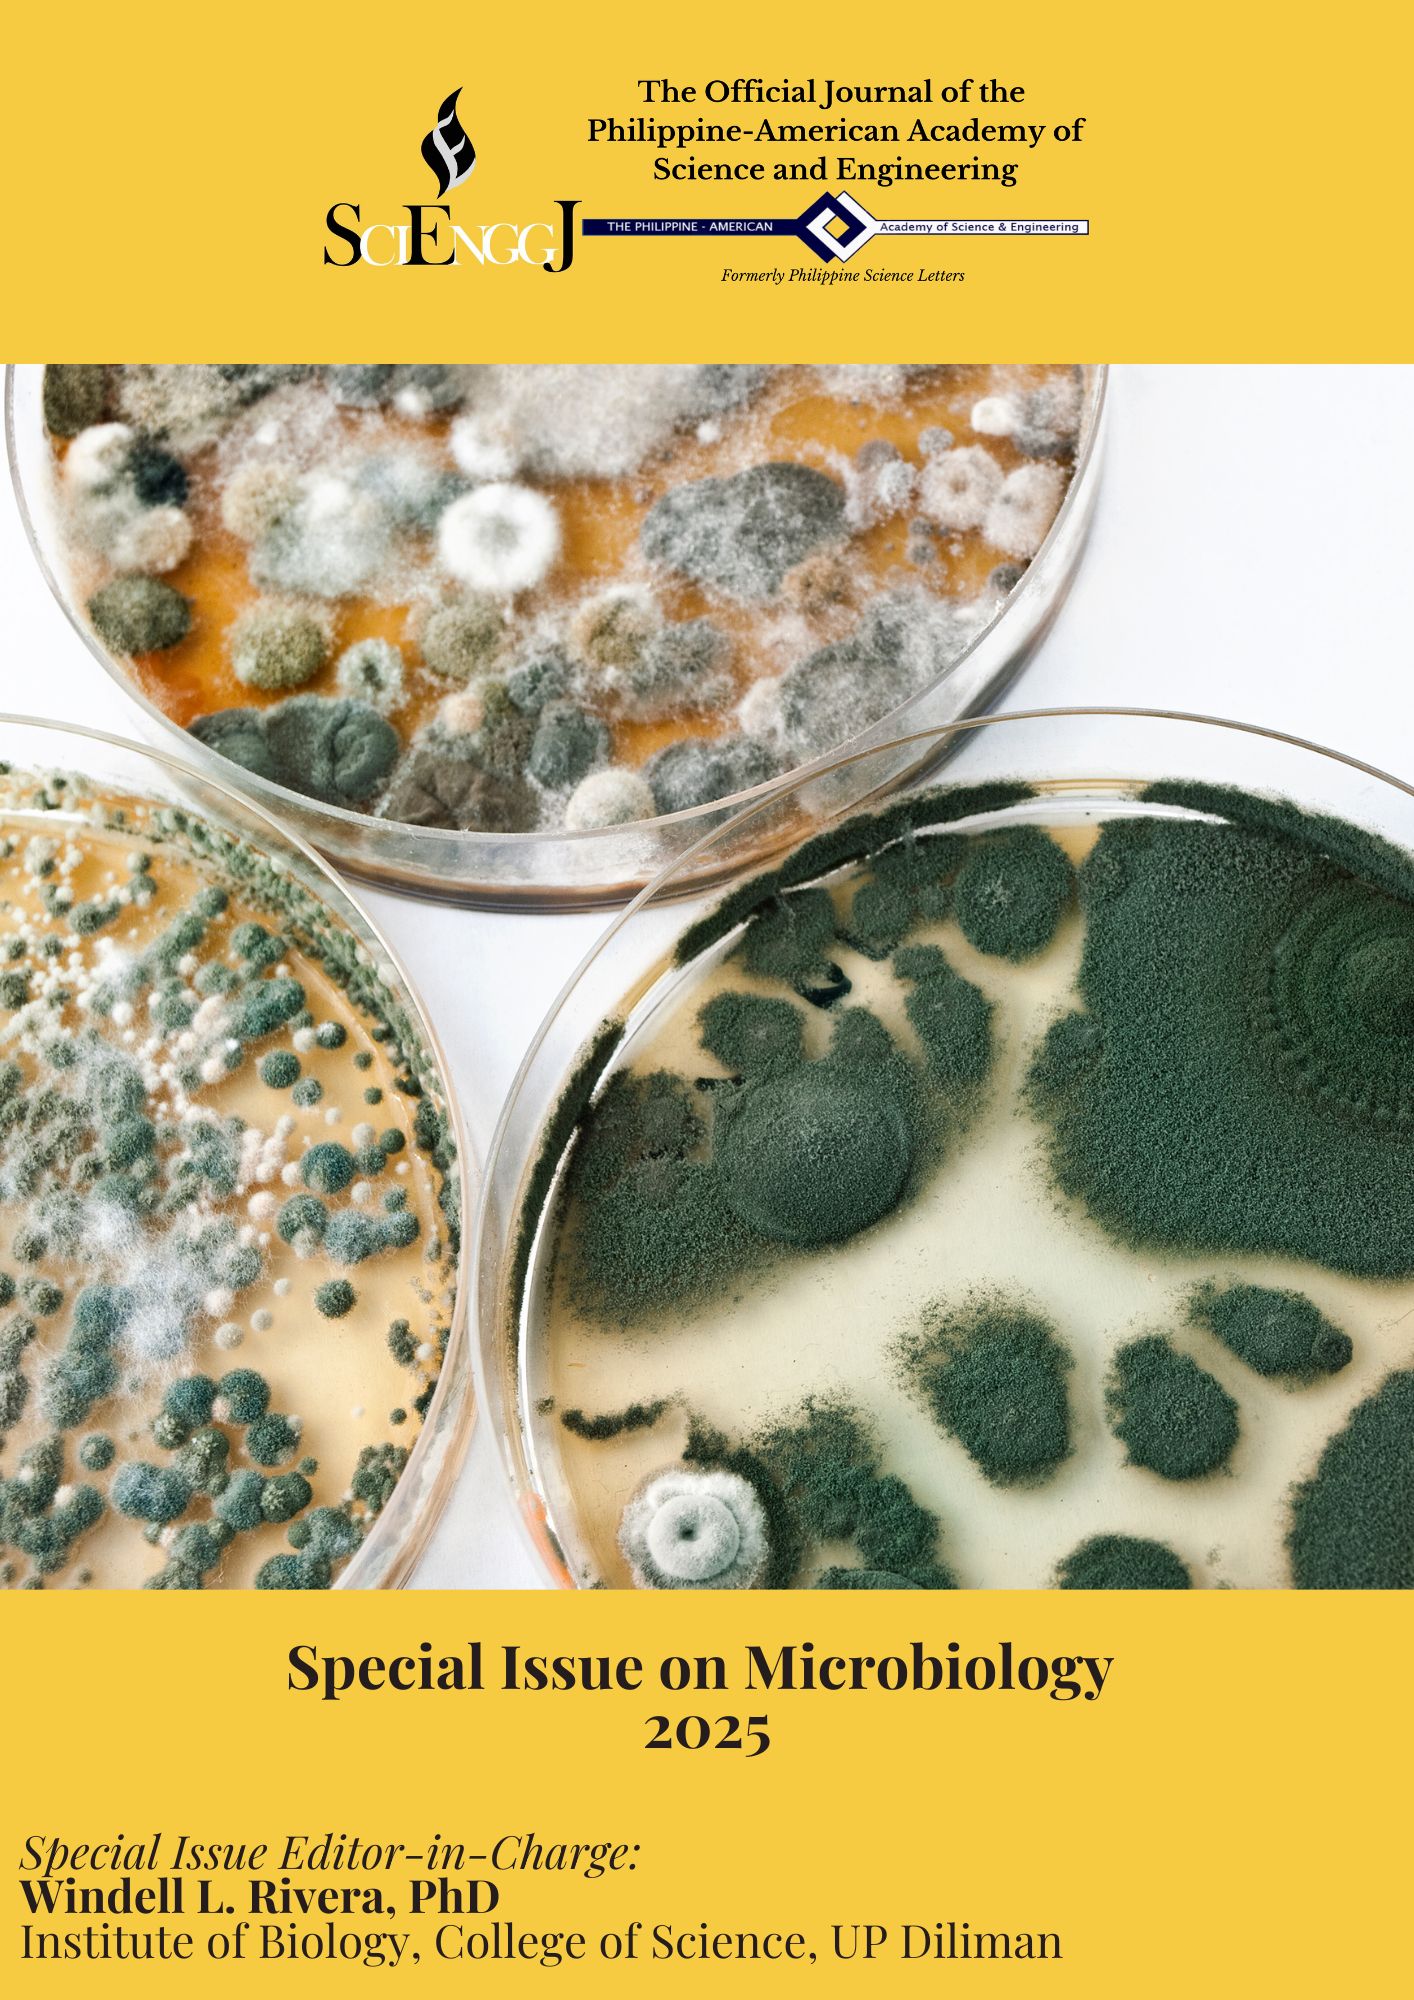
Special%20Issue%20S%26E%20Education%202024 2025
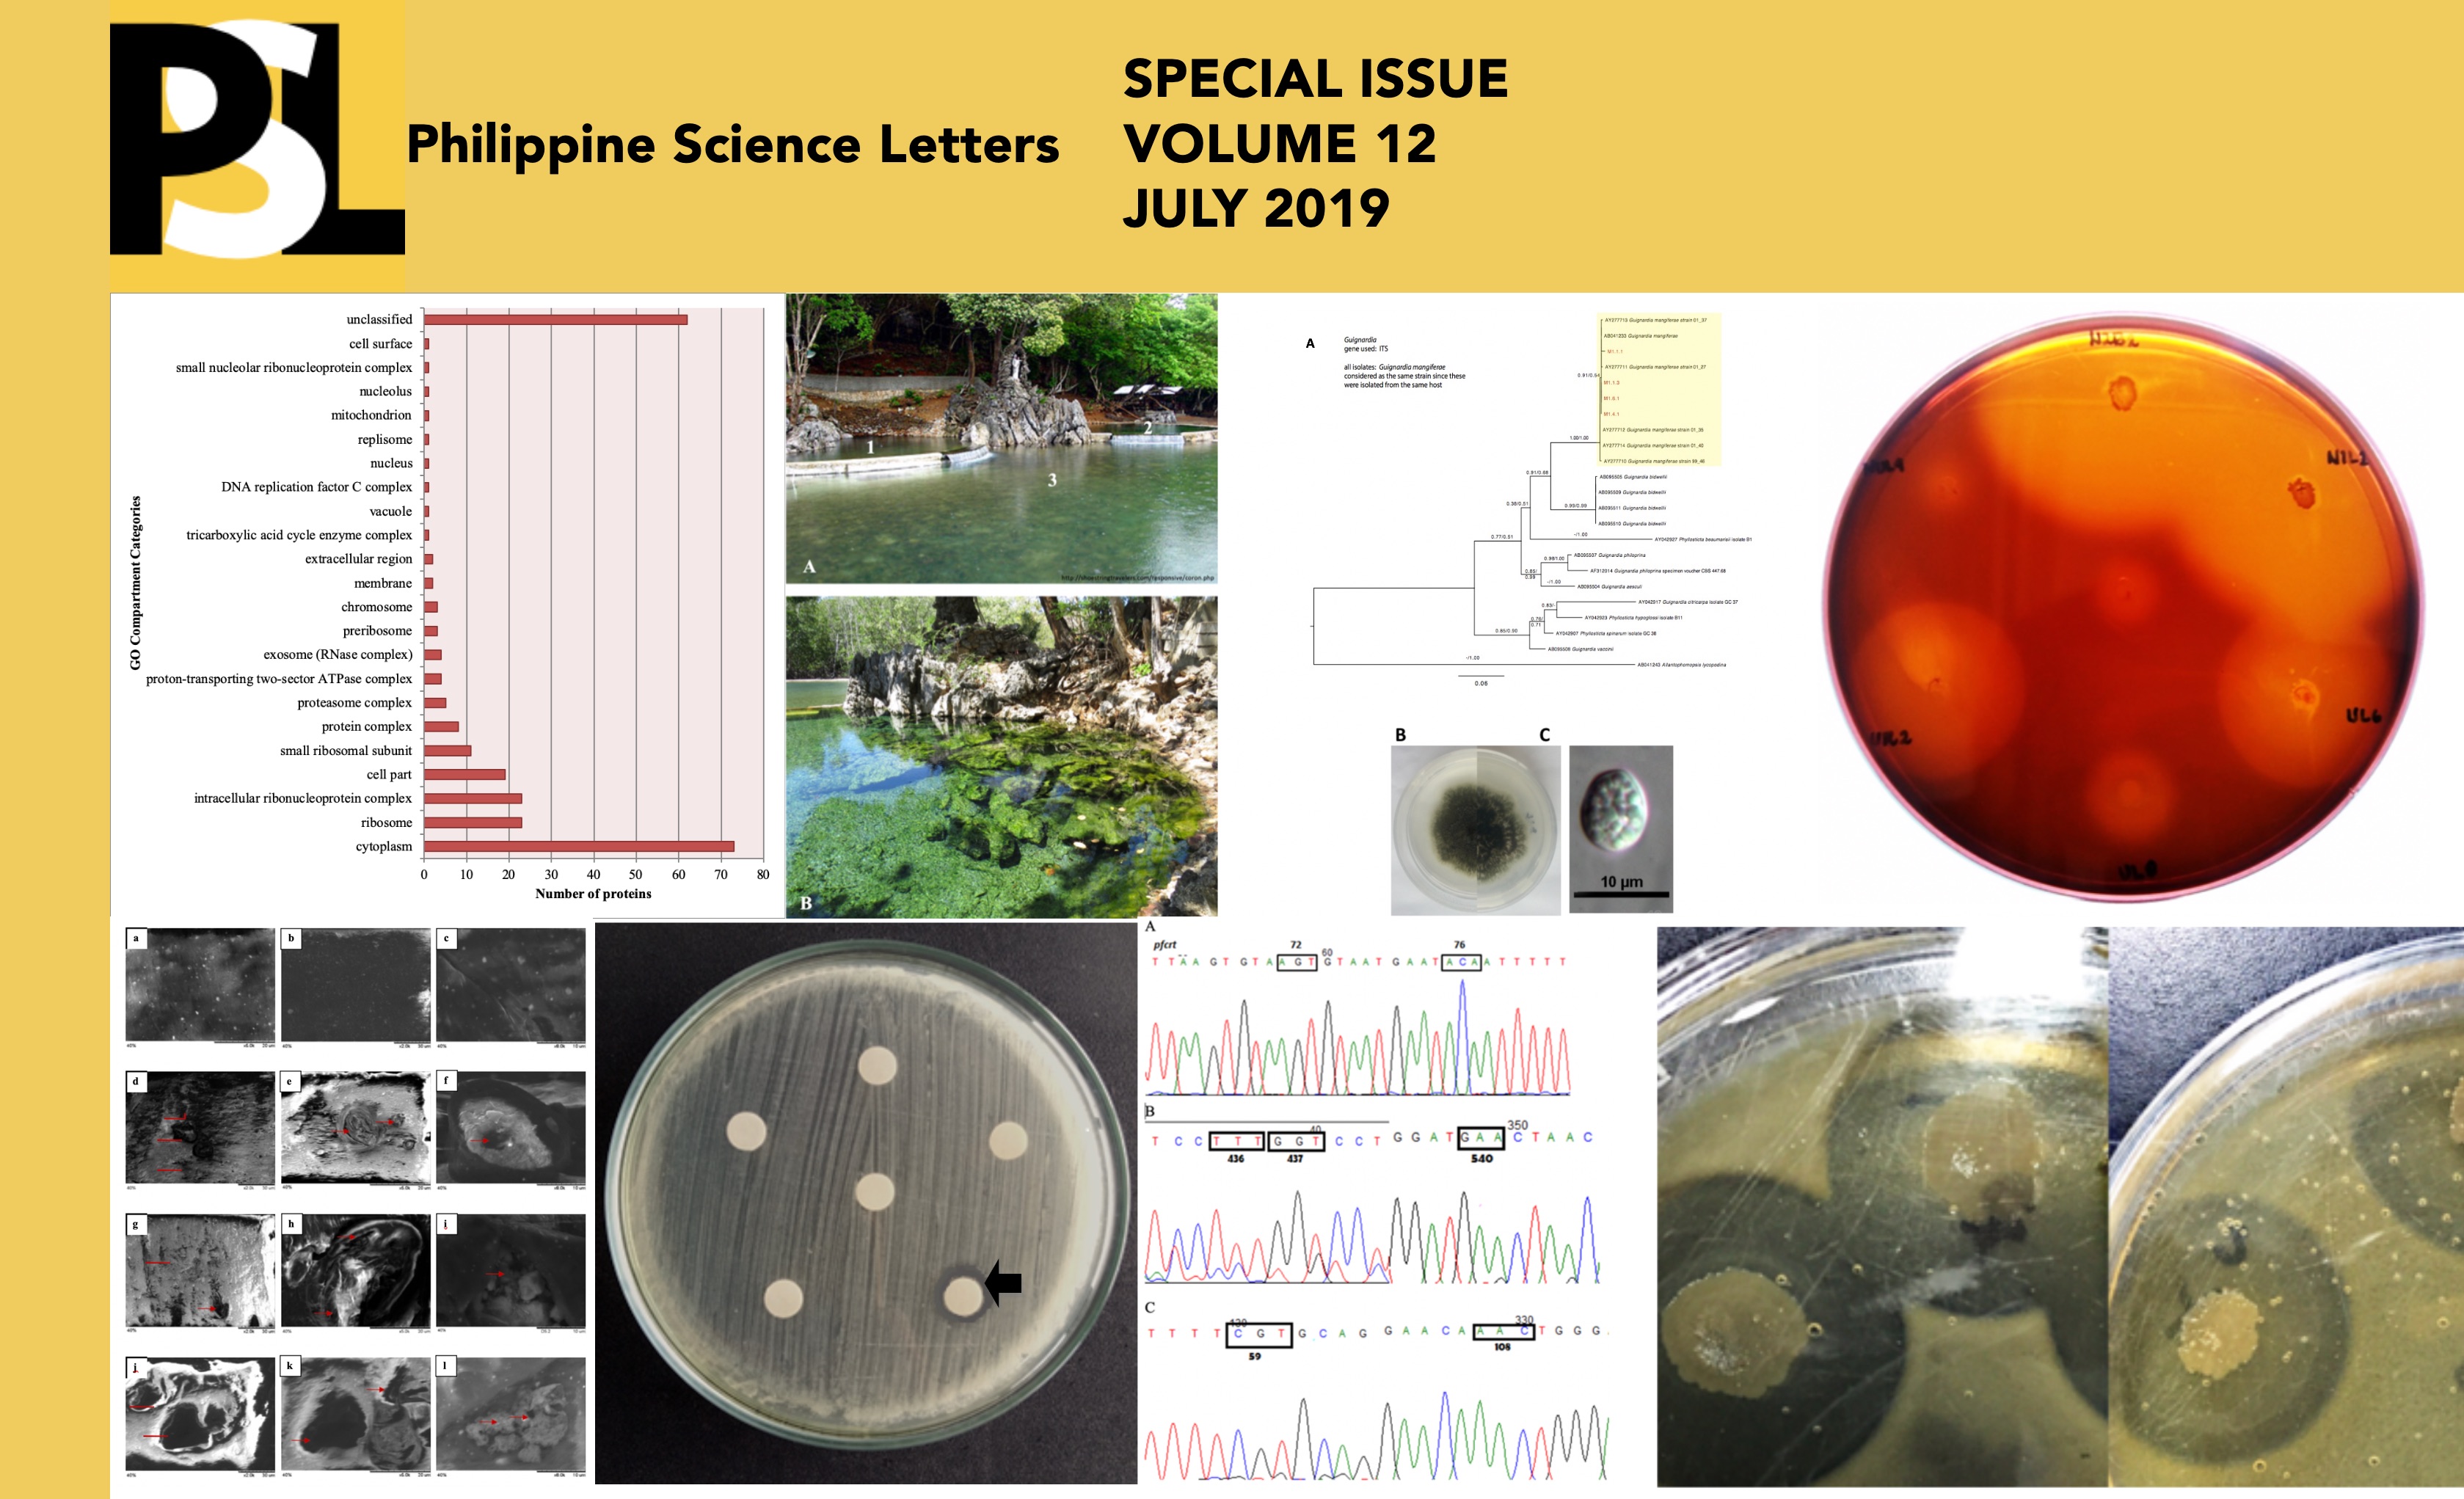
Special%20Issue%20Placeholder%202

SciEnggJ is committed to fostering high-quality research and scholarly discourse in the fields of science and engineering. To achieve this goal, we invite proposals for special issues that delve into specific themes or topics of significance within our domain. When submitting a proposal for a special issue, it is important to clearly define the scope and rationale behind the proposed theme. We encourage guest editors with expertise in the relevant area to spearhead these initiatives, ensuring that the special issue maintains the rigorous standards and academic integrity associated with SciEnggJ.
The proposal should outline a tentative timeline for the special issue, including key milestones such as submission deadlines, review periods, and the expected publication date. Additionally, identifying potential contributors who can provide high-quality submissions within the theme of the special issue is crucial for its success. Once the proposal is accepted, the guest editor(s) will collaborate with our editorial team to craft a compelling call for papers. This call should articulate the theme, objectives, and focus areas of the special issue, aligning with the journal's scope and interests.
Submission guidelines should be provided to authors, detailing manuscript formatting instructions, word limits, referencing styles, and any other specific requirements. A transparent peer review process is essential to ensure the quality and originality of submissions. Authors should be kept informed about the status of their submissions throughout the review process, receiving timely updates and feedback. Once accepted, authors will be guided through the final manuscript preparation process, including formatting and copyright requirements.
To maximize the impact and visibility of the special issue, we will employ various marketing strategies, including promotion through our website, social media platforms, mailing lists, and academic networks. Additionally, we will ensure that the special issue is indexed in relevant databases and archives for maximum discoverability and long-term preservation. Ethical considerations, such as plagiarism detection and conflict of interest disclosures, will be strictly enforced throughout the publication process.
After publication, we will monitor feedback and metrics to evaluate the impact and reach of the special issue. This feedback will inform continuous improvements to our processes and help shape future special issues. Ultimately, our goal is to facilitate the dissemination of cutting-edge research and promote scholarly dialogue within the fields of science and engineering through our special issue initiatives.
Jump to SPECIAL ISSUES
2026 | 2025 | 2024 | 2023 | 2022 | 2021 | 2020 | 2019 | 2018

ARTICLE
Grading efficiency and accuracy: Teachers’ ZipGrade app experiences
by Rizaldy E. Garcia and Mirasol P. Garcia
Pages 74-83

ARTICLE
by Lency S. Rosana, Edcyl Lee O. Salac, Gabrielle Troy A. Cuevas, Maridel S. Somejo, Jay O. Martizano, Rea Grace P. Galit, Shairra Joy G. Bacuta, Sherwin L. Escayo, and Elmer-Rico E. Mojica
Pages 64-73
ARTICLE
by Diana Hasim, Adzmin Fatta, Nadhirah Rifai, Alvin Jeyanathan Chelliah, Julian Hyde, and Chen Sue Yee
Pages 90-96

ARTICLE
Mechanisms regulating understory plant diversity in three forest types: a simulation study
by Gimelle B. Gamilla-Amorosa and Jerrold M. Tubay
Pages 44-54
ARTICLE
Using machine learning models for near-term forecasting of dengue cases in Quezon City, Philippines
by Andrea Nicole G. Senson, Rafael Ma. Vicente D. Tagulao, Francis Ira S. Velaque, Rolando V. Cruz, Wilson J. Villaganes, Jr., Johnedel N. Mendoza, Elvira P. De Lara-Tuprio, Timothy Robin Y. Teng, and Mark Anthony C. Tolentino
Pages 108-122

ARTICLE
by Carolina B. Capili, Louis Andrew M. Olazo, Joseph Edwin L. Bascuña, Chona Mae Daga, Mariza Garing, Alma G. Palparan, Vina Lea F. Arguelles, Catherine C. Dacasin, Soledad Rosanna Cunanan, and Ramon P. Basilio
Pages 34-43

ARTICLE
by Carlos Miguel G. Orale, Eliza Rose Y, Aquino, Lilian N. Dela Cruz, Miguel L. Estrada, Hannah Lorraine C. Frias, Aleck Andrei R. De Guzman, Allyzxia Venisse H. Navarro, Ma. Angela Klarizze H. Solomon, Allan S. Gilles Jr., Justine de Leon, Dino T. Tordesillas, Rey Donne S. Papa, and Elfritzson M. Peralta
Pages 23-33



ARTICLE
Analysis of the variation of age-specific life expectancies between sexes due to the COVID-19 pandemic in the National Capital Region, Philippines
by Aubrey Christine C. Tatoy and Wilfredo Y. Licuanan
374
ARTICLE
Development and validation of an HPLC-PDA method for the quantification of fluconazole and application to fluconazole-loaded buccoadhesive film
by Gerwin Louis T. Dela Torre, Bryan Paul I. Bulatao, Julius Andrew P. Nuñez, and Jean Flor C. Casauay
380
ARTICLE
In vitro inhibition of α-glucosidase by Rubus rosifolius leaf and fruit extracts
by Louie R. Delgado, Franz Heinrich R. Nimer, Joshua M. Jimenez, Marvi Ann C. Zurita, and Angeli Ann S. Rescober
386
ARTICLE
Knowledge, disposition, and adherence of Filipino health professionals living with human immunodeficiency virus on antiretroviral therapy: A sequential explanatory mixed methods study
by Agnes V. Valencia-Raymundo, Lheanne Ruth I. Castil, Renei Iza N. De Jesus, Carla Marie L. Calosa, and Gia Margarette P. Cruz
393
ARTICLE
Optimization of ultrasonic-assisted green synthesis of Au-ZnO bimetallic nanoparticles using pineapple (Ananas comosus) peels extract
by April Mergelle R. Lapuz, Julius D.G. Contreras, Queenzy T. Trinidad, Jenela Mae F. Bañes, Farha E. Nour, and Jerome D. Fundano
408
ARTICLE
Serum ferritin, insulin, and c-reactive protein as early biochemical indicators for gestational diabetes mellitus among a Filipino population in Manila
by Nini F. Lim and Maria Ruth B. Pineda-Cortel
419

ARTICLE
Sensitivity analysis of an epidemic model with a mass vaccination program of a homogeneous population
by Ma. Cristina R. Bargo
325
ARTICLE
Mathematical modeling of soil-transmitted helminth infection: Human-animal dynamics with environmental reservoirs
by Rafiatu Imoro, Maica Krizna A. Gavina, Vachel Gay V. Paller, Jomar F. Rabajante, Mark Jayson V. Cortez, and Editha C. Jose
350
ARTICLE
Modeling pertussis transmission in the Philippines: Insights on epidemic dynamics and vaccination impact
by Micko Jay S. Bajamundi, Robert Neil F. Leong, Mark Lexter D. De Lara, Ranzivelle Marianne Roxas-Villanueva, Marie Joy Lopez-Relente, Allen L. Nazareno
362
ARTICLE
Dengue incidence in Baguio City: An application of a compartmental model to Baguio City data for years 2011 to 2022
by Junius Wilhelm G. Bueno, Ronmar B. Macarubbo, Mark Ian C. Barreto, Gerald S. Navida, Andrei A. Domogo, and Priscilla S. Macansantos
427
ARTICLE
Flexible decay metrics for early prediction of gestational trophoblastic neoplasia: A comparative modeling approach
by Alvin Duke R. Sy, Fernando B. Garcia, Jr., Clarissa L. Velayo, Michael Daniel C. Lucagbo, Abubakar S. Asaad, and Maria Stephanie Fay S. Cagayan
469
ARTICLE
Age-structured modeling of tuberculosis transmission in the Philippines
by Miles Lyndon C. Angeles, Roland James Olita, Jcob C. Malaguit, Monica C. Torres
483
ARTICLE
Modelling time to β-hCG remission in gestational trophoblastic disease: Comparative evaluation of Cox and parametric survival approaches
by Alvin Duke R. Sy, Michael Daniel C. Lucagbo, Abubakar S. Asaad, Clarissa L. Velayo, Fernando B. Garcia, Jr., and Maria Stephanie Fay S. Cagayan
500
ARTICLE
Philippine marine natural product scaffolds as inhibitors of DNA damage response pathways with promising binding propensity, stability, and pharmacokinetic profiles
by Juliana Laine G. Rublico, Francesca Danielle S. Baysa, Jamielle C. Sarga, Casandra Marie B. Sibug, Edward Brian M. Ranjo, Mark Tristan J. Quimque, Jay Carl M. Agbay, Joe Anthony H. Manzano, and Carl Jay Laurenciano
515

ARTICLE
Development of a microfluidic platform for the encapsulation of baker’s yeast Saccharomyces cerevisiae in alginate hydrogel microparticles
by Alexandra Melise D. Hulog, Miguel Francisco Jose P. Ordoñez, Noel A. Oquendo, Mariane Desiree C. Avendaño, Jamielyn N. Kaw, Alwin Darren O. Dagdag, and Ricardo Jose S. Guerrero
256
ARTICLE
Scaffold-free generation of non-contractile bioengineered cartilage to investigate the effects of inflammatory mediators on human chondrocytes
by Stephanie Richardson-Solorzano, Dilpreet Rayat, Alvin W. Su, and Justin Parreno
311
ARTICLE
Phenotypic expression of biofilm formation and ESBL-linked resistance in Escherichia coli isolated from meat
by Paul Joshua Balosbalos, John Paul Y. Fernandez, Krystel Grace V. Padilla, Danny O. Alfonso, and Rachelle M. Conmigo
338
ARTICLE
Molecular docking identifies dicumarol and demethylwedelolactoneas candidate binders of the HPV16 E6–p53 interface
by Honeylaine O. Arcilla, Conrad Allan Chong, Rod Vincent Borromeo, Jessa Louise Cadacio, Ranelle Janine L. Asi, Jeffrey Clement C. Bungar, Javier Lozano-Gerona, and Ahmad Reza F. Mazahery
440
ARTICLE
Simulation analysis reveals catechin from crude Mentha cordifolia has potential antiretroviral properties against HIV and suggests possible protease inhibition through flap and active site interactions
by Jeffrey Clement Bungar, Vincent Borromeo, Ranelle Janine Asi, Sheriah Laine de Paz-Silava, and Ahmad Reza Mazahery
456

ARTICLE
Astronomy and astrophysics publication research metrics among southeast Asian countries
by Ryan Manuel D. Guido
148
ARTICLE
Orbital evolution of R Aquarii
by Princess B. Tucio, Custer Deocaris, and M.B.N. Kouwenhoven
196
ARTICLE
The development and evaluation of a digital review material utilizing mobile application
by Samuel A. Babin, Magno M. Quendangan, and Rizaldy E. Garcia
202
ARTICLE
Darkest nights of the Marawi siege
by Jason B. Kalaw and Ryan Manuel D. Guido
246

ARTICLE
Design and development of web-based problem-solving ability test instruments on fluid Physics material
by M Misbah, Ida Hamidah, Siti Sriyati, and Achmad Samsudin
1
ARTICLE
Exploring trends, impact, and applications of artificial intelligence (AI) in language learning: From concept, definition, examples, to a comprehensive bibliometric analysis
by Nuria Haristiani, Dwi Novia Al Husaeni, H. Herniwati, S. Sugihartono, Amirulloh Abduh
21
ARTICLE
Performance analysis of massive MIMO hybrid neamforming using regularized zero forcing and phased zero forcing
by Endah Setyowati, Gita Alisrobia Nazarudin, Galura Muhammad Suranegara, and Ahmad Fauzi
49
ARTICLE
Citizen science project-based digital encyclopedia of mammals: Improving students' species literacy
by Fitri Aryanti, Topik Hidayat, Yayan Sanjaya, and Kusnadi
54
ARTICLE
Design of lesson plans for Internet of Things products in science learning by teachers to improve the quality of education
by Diana Rochintaniawati, Aay Susilawati, Iwan Kustiawan, and Lilik Hasanah
120
ARTICLE
Renewable energy sources, technological innovations, role, and their impact on sustainable development goals (SDGs): From concept, definition, examples to a comprehensive bibliometric analysis data
by Meli Fiandini, Rika Rafikah Agustin, Asep Bayu Dani Nandiyanto
128
ARTICLE
Particle technology in catalyst design for water treatment application: Review and bibliometric analysis
by Risti Ragadhita, Asep Bayu Dani Nandiyanto*, and Ahmad Mudzakir
170
ARTICLE
Number pattern through realistic mathematics education: A hypothetical learning trajectory
by Ratu Sarah Fauziah Iskandar, Darhim, Jarnawi Afgani Dahlan, and Al Jupri
188
ARTICLE
Artificial intelligence-integrated interactive multimedia to improve conceptual understanding in eighth-grade science learning
by Satwika Trianti Ngandoh, R. Riandi, Adi Rahmat, M. Muslim
219
ARTICLE
FTIR analysis of pyrolyzed LLDPE and polystyrene microparticles and their chemical reaction mechanism completed with computational bibliometric literature review to support sustainable development goals (SDGs)
by Asep Bayu Dani Nandiyanto, Andini Salsabila, Stevani Veronica, Farhan Muzhaffar Tiras Putra, Ida Kaniawati, Teguh Kurniawan, Obie Farobie, and Muhammad Roil Bilad
289
ARTICLE
Exploring biomass-based brake pads from various construction wastes in microparticle sizes: Advancing environmentally friendly solutions and student entrepreneurship for sustainable development goals (SDGs)
by Senny Luckyardi, Muhamad Fahrezi, Eddy Soeryanto Soegoto, Brandon Nathanael Meliala, Fadhil Fadhilah Ilham, Risti Ragadhita, and Asep Bayu Dani Nandiyanto
299
ARTICLE
Evaluation of in vitro antibacterial activity and in vivo Caenorhabditis elegans assays of Bacillus velezensis AU1 and AU2
by Avvy Sheen B. Uy, Louise M. Anoos, Nephriteri G. Generale, Mark I.R. Petalcorin, and Fleurdeliz Maglangit
9
ARTICLE
Halotolerant bacteria from saline soils in Ballesteros, Cagayan, Philippines
by Luis Angelo A. Cortez, Jacqueline S. Rojales, Vicky T. Dimaano, Digna R. Allag, Jerry Paul P. Arciaga, Edna D. Samar, and Karen S. Bautista
32
ARTICLE
A metagenomic analysis of the microbial community structures in the winemaking stages of ‘Baya’: An indigenous heritage rice wine of Batad, Ifugao, Philippines
by Shaira Ann D. Rueco, Lyndsay P. Bernabe, Jennielle Klaude M. Gonzales, Jeno Rey R. Pagaduan, and Ronie J. Calugay
74
ARTICLE
Bacterial pathogens of non-native rodents and shrews of Busol Watershed and Forest Reservation, Baguio City
by Kimberly P. Paglingayen, Rosemary M. Gutierrez, and Ronie J. Calugay
107
ARTICLE
Plasmid paradox: Persistence of recombinant plasmid without antibiotic selection elevates tellurite resistance in Escherichia coli strain A1 mutant
by Madison P. Munar
161
ARTICLE
Evaluation of antibacterial activity of black soldier fly (Hermetia illucens L.) larval gut extracts
by Jaymark Orapa, Nephriteri Generale, Avvy Sheen Uy, Danielle Dalman, Mariel Rose Villarubia, Fleurdeliz Maglangit
270
ARTICLE
Exploratory authentication of lactic acid bacteria in commercial probiotic drinks sold in the Philippines
by Trizia Angela S. Edra, Jennifer Helyn R. Saladaga, Julianne Jesh D. Villena, Melizza Jane M. Collo, Jorge Anton D. Ordas, and Aimee Caye G. Chang
277
ARTICLE
A comparative study of culture-based and PCR-based protocols for Salmonella enterica detection in meat, environmental swabs, and commercial animal feed
by Jonah Feliza B. Mora, Pauline Dianne M. Santos, Remedios F. Micu, and Windell L. Rivera
493
ARTICLE
Potential reduction of chemical fertilizer use by applying Trichoderma microbial inoculant (TMI) in UPLB Lagkitan variety native corn cropping
by Virginia C. Cuevas, Merdelyn T. Caasi-Lit, Angelyn Marta D. Marmeto, Bernard B. Panabang, Weaver Joram C. Marasigan, and Ireneo L. Lit, Jr.
539

FOREWORD
by Juan M. Pulhin
i
ARTICLE
Visualizing the cascading impacts of multi-hazards in three selected barangays in the Quinali A Watershed, Albay, Philippines
by Kyle Vincent R. Singson, Juan M. Pulhin, Maricel T. Villamayor, Catherine S. Anders, Rose Jane J. Peras, Liezl B. Grefalda, Lorena L. Sabino, Josephine E. Garcia, and Florencia B. Pulhin
61
ARTICLE
Policy implications of drought's cascading effects on sustainable livelihoods and natural resource management in South-Central Mindanao, Philippines
by Lorena L. Sabino, Lara Paul A. Ebal, Noel G. Sabino, Maricel T. Villamayor, Liezl B. Grefalda, and Juan M. Pulhin
86
ARTICLE
Analysis of the contemporary drivers of deforestation and forest degradation in Southern Sierra Madre Region, Philippines
by Marie Jessica C. Gabriel, Kyle Pierre R. Israel, Beth Zaida H. Ugat, Wencelito P. Hintural, and Michael Maoi M. Baldonado
225
ARTICLE
Mangrove extent mapping using different mangrove vegetation indices and sentinel-2 for ecosystem accounting in Occidental Mindoro, Philippines
by Adrian Pablo V. Sasi, Cristino L. Tiburan Jr., Gem B. Castillo, Canesio D. Predo, Asa Jose U. Sajise, Juan M. Pulhin, Arnan B. Araza, Catherine S. Anders, Rosario V. Tatlonghari, Dannica Rose G. Aquino, Grace Anne S. Malolos, Karen M. Pajadan, Christian Ray C. Buendia, and Pauline Cielo P. Palma
235

ARTICLE
Performance analysis of single cylinder engines with enhanced heat dissipation fins using computational fluid dynamics
by Nitish Reddy Pasham, Gondi Konda Reddy, and Jayakiran Reddy Esanakula
1
ARTICLE
A single switch high gain multilevel boost converter with switched inductor topology for photovoltaic applications
by Akkela Krishnaveni and Rajender Boini
8
ARTICLE
Analysis of statistical estimators and neural network approaches for speech enhancement
by Ravi Kumar Kandagatla, V. Jayachandra Naidu, P.S. Sreenivasa Reddy, Gayathri M., Jahnavi A., and Rajeswari K.
17
ARTICLE
Analysis of EEG signals for the detection of epileptic seizures using feature extraction
by Ravi Kumar Kandagatla, V. Jayachandra Naidu, PS. Sreenivas Reddy, Veera Kavya Pandilla, Marriwada Joshitha, and Chanamala Rakesh
28
ARTICLE
An evolutionary and insightful graph neural network based hybrid model for deciphering tenacious stress detection of humans using facial emotion recognition: coinage to affective computing
by Megha Bansal and Vaibhav Vyas
96
ARTICLE
Static analysis of new lightweight racing wheel for Formula Society of Automotive Engineers (FSAE) race car for product innovation
by Muhammad I. N. Ma’arof, Anies F. Zakaria, Girma T. Chala, Riang Liang, Nurzaki Ikhsan, and Mohamad F. M. Nasir
148

ARTICLE
Overexpressed yeast Bax inhibitor (Bxi1p/Ybh3p) is a calcium channel in E. coli
by James Mullin, John Kalhorn, Julia Aguiar, Madelyn Crago, Nicholas Mello, Amanda Raffa, Alexander Strakosha, and Nicanor Austriaco, O.P.
36
ARTICLE
Molecular characteristics of carbapenem-resistant Enterobacteriaceae isolated from two tertiary hospitals in the Philippines
by Angelo dV. dela Tonga, Windell L. Rivera, Ma Jowina H. Galarion, Stessi Marie G. Geganzo, Melanie V. Salinas, Edsel Maurice T. Salvaña, and Raul V. Destura
89
ARTICLE
Assessment of the functional properties of probiotic-loaded alginate beads and their effects on the growth performance of juvenile Nile tilapia (Oreochromis niloticus)
by Nico G. Dumandan, Caren R. Tumambing, Ivan Duanne F. Arriola, and Ranelle DP. Acda
194
ARTICLE
Unveiling the genomic landscape: Whole genome draft and phenotypic profiling of Oceanobacillus sp. SE10311 isolated from Mount Makiling, Philippines
by Noel H. Tan Gana, Cernan P. Ruz, Eufrocinio C. Marfori, Edwin P. Alcantara, Maria Genaleen Q. Diaz, Lucille C. Villegas, Eldrin DLR. Arguelles, Armi R. Creencia, Neil H. Tan Gana, Rosario G. Monsalud, and Rina B. Opulencia
304
ARTICLE
Fecal coliform assessment and detection of blaTEM, blaSHV, and tetA in Escherichia coli isolated from selected river waters of Tacloban City, Leyte, Philippines
by Jordan D. Vivo and Windell L. Rivera
321
ARTICLE
Isolation of griseofulvin from the endolichenic fungus Cubamyces menziesii (Berk.) Lücking inhabiting Parmotrema rampoddense (Nyl.) Hale
by Mario A. Tan, Jake Darryn dela Cruz, Hilbert D. Magpantay, Carlo Chris S. Apurillo, Thomas Edison E. dela Cruz
432

ARTICLE
Synthesis and biological evaluation of cyanobacterial-inspired peptides
by Jannelle R. Casanova, Aaron Joseph L. Villaraza, and Lilibeth Salvador-Reyes
42
ARTICLE
Diversity and novelty of venom peptides from Conus (Asprella) rolani revealed by analysis of its venom duct transcriptome
by Ryoichi S. Taguchi, Dan Jethro M. Masacupan, and Arturo O. Lluisma
120
ARTICLE
In vivo anti-tumor and anti-metastatic activity of renieramycin M and doxorubicin combination treatments on 4T1 breast cancer murine model
by Zildjian G. Acyatan, Shalice R. Susana-Guevarra, Myra Ruth D. Picart, Eliza L. Belen, Lilibeth A. Salvador-Reyes, and Gisela P. Concepcion
379

ARTICLE
Depression and anxiety among Filipino myasthenia gravis patients seen in a public tertiary hospital in Metro Manila
by Karen Joy B. Adiao, Adrian I. Espiritu, and Mario B. Prado, Jr.
103
ARTICLE
Predictors of interdependent happiness among health science students during the COVID-19 pandemic
by Demuel Dee L. Berto, D. Darwin A. Dasig, Leticia T. Ibanez, Marlon L. Bayot
112
ARTICLE
Intradialytic massage for leg cramps among hemodialysis patients: A single-center, randomized crossover trial
by Krizia Mari Anne Ramos-Daguman, Ed Jico B. Conde, Henry Angelo S. Go, Vince Bryan B. Viscayno, Monalisa L. Lim Dungca, Marissa Elizabeth L. Lim
131
ARTICLE
Key informant perspectives on delivering adolescent pregnancy-related services in Eastern Visayas
by Alvin Duke R. Sy, Kim Leonard G. dela Luna, Rowel C. Malimban, John Oliver H. Estadilla, Jasper M. Maglinab, Jihwan Jeon, and Heyeon Ji
139
REVIEW
Association of first-trimester screening biomarkers and the prevalence of cerebral palsy and other neurodevelopmental conditions: A systematic review
by John Patrick R. Lentejas and Clarissa L. Velayo
155
ARTICLE
Sheng Zhen Gong in pregnancy: The effects of a traditional low intensity exercise form on maternofetal health and wellbeing
by Clarissa L. Velayo, Sherri Ann L. Suplido, Alvin Duke R. Sy, Ourlad Alzeus G. Tantengco, Ruben N. Caragay, and Manuela T. Zuniga
163
ARTICLE
Impact of the organ-system integrated curriculum on the research productivity of a Philippine government medical school: An ARIMA-based bibliometric analysis
by Christian Wilson R. Turalde, Al Joseph R. Molina, Mario B. Prado, and Erlyn A. Sana
176
FEATURE
On the shoulder of giants: A brief early history of leadership in the Department of Physiology of the University of the Philippines College of Medicine
by Clarissa L. Velayo, MD, PhD
184
ARTICLE
Role of FGF23 and alkaline phosphatase in bone health: Case-based clinico-physiologic discussion
by Mark Anthony S. Sandoval and Irewin A. Tabu
188
REVIEW
Ethnomedicinal plants used for treating urinary tract infections in the Philippines: a systematic review
by Mariel C. Magtalas, Manuel Luis A. Borja, Juan Raphael M. Perez, Elgin Paul B. Quebral, and Ourlad Alzeus G. Tantengco
202
ARTICLE
Structural and molecular alterations in murine tissue due to far-field radiofrequency exposure
by Aaron Paul T. Baliga, Roy Francis R. Navea, Clarissa L. Velayo
331
ARTICLE
A systematic review and meta-analysis on the prevalence of vulvovaginal candidiasis in Southeast Asian countries
by Robbi Miguel G. Falcon, Renne Margaret U. Alcazar, Justin V. Guda, and Ourlad Alzeus G. Tantengco
341
ARTICLE
The efficacy of methylxanthines as adjunct to standard of care in improving outcomes among chronic obstructive pulmonary disease patients at high risk for and in acute exacerbation: A systematic review and meta-analysis of randomized and non-randomized studies
by Mithi Kalayaan S. Zamora, Joel M. Santiaguel, Manuel Peter C. Jorge, and Daniel Y. Guevara
362
ARTICLE
Uterocervical angle as a second trimester screening method for the prediction of preterm birth in a Filipino population in a tertiary government hospital
by Deverly Rina V. Reyes and Clarissa L. Velayo
368
ARTICLE
Anxiety, depression, and family dysfunction among COVID-19 patients admitted to hospital and isolation facilities in the Philippines
by Ian Kim B. Tabios, Ourlad Alzeus G. Tantengco, Anna Guia O. Limpoco, Gabriele Dominique P. Domingo, Eric David B. Ornos, and Leilanie Apostol-Nicodemus
391
ARTICLE
Early experience of fetal laser photocoagulation for twin-to-twin transfusion syndrome in the Philippines
by Clarissa L. Velayo, Karen Alessandra T. Torredes, Christine Vivienne F. Tantoco
400
ARTICLE
A 5-year review of preeclampsia screening in a tertiary private hospital in the Philippines: A retrospective cohort study
by Sheila O. Ramos and Clarissa L. Velayo
407
ARTICLE
A review of maternal Zika virus infection and its fetal outcomes
by Marissa Elizabeth L. Lim, Arlene I. Afaga, and Jon Timothy M. Rivero
417

ARTICLE
Scientific experiment measurement of optical signal characteristics on fiber optic access network prototype for distance learning education purposes
by Ahmad Fauzi, Endah Setyowati, Desiana Fajar Wisdawati, and Muhammad Dzikri Danuarteu
461
ARTICLE
Intent-based networking and reactive forwarding performance comparison on resolving multi-link failure
by Galura Muhammad Suranegara, Salwa Tasya Fathira Purba, Endah Setyowati, and Diky Zakaria
466

ARTICLE
Land cover change and carbon loss: A case study of the Pagsanjan-Lumban and Baroro watersheds in Luzon, Philippines
by Florencia B. Pulhin, Angelica T. Magpantay, Nico R. Almarines, Canesio D. Predo, and Juan M. Pulhin
268
ARTICLE
Catalysts and barriers in the development and implementation of payment for water ecosystem services in the Philippines: Retrospects and prospects
by Juan M. Pulhin, Asa Jose U. Sajise, Canesio D. Predo, Catherine S. Anders, Rosario V. Tatlonghari, Marlo D. Mendoza, Fritzielyn Q. Palmiery, Sheerah Louise C. Tasico, Mary Beatrice S. Evaristo, Joylyn Bon O.L. Yu, and Farah Y. Sevilla
281
ARTICLE
Typhoon-induced mangrove changes and its impacts on livelihood resources in Palawan, Philippines
by Pia C. Montoya and Rajendra P. Shrestha
443
ARTICLE
Developing sustainability indicators for people’s organizations engaged in natural resource management: The case study of Ned Landcare Association, Lake Sebu, South Cotabato, Philippines
by Louise Bernadette C. del Castillo and Lorena L. Sabino
474
ARTICLE
Forest restoration assessment in selected critical watersheds in the Philippines using NDVI and Google Earth Engine
by Kyle Pierre R. Israel, Cristino L. Tiburan Jr., Enrique L. Tolentino Jr., and Nathaniel C. Bantayan
571
ARTICLE
Trading green for gold: The lived experiences of migrant indigenous peoples with large-scale mining operations in Runruno, Quezon, Nueva Vizcaya, Philippines
by Aureneil C. Natividad, Lorena L. Sabino, Ma. Larissa Lelu P. Gata, Felisa L. Malabayabas, and Patricia Ann J. Sanchez
537
ARTICLE
Bridging borders for sustainable river basin management: Lessons from the Cagayan River Basin
by Orlando F. Balderama, Lanie A. Alejo, Czarimah L. Singson, Arlen S. Alejandro, Carlo C. Ablan, Sameh Ahmed Kantoush, Tetsuya Sumi, and Doan Van Binh
551

ARTICLE
MicroRNA-21, C-C chemokine receptor type 7, and twinfilin actin binding protein 1 expression in fresh frozen breast tissue samples
by Romar G. Dabban, Michael O. Baclig, and Ma. Luisa D. Enriquez
356
ARTICLE
Preformulation studies of an emulsion containing commercially available argan oil
by Mikaela Mae Suasin, Mikhaela Camille Tanael, Lea Vanessa Jaro, Desiree Nicole Esteve, April Mergelle Lapuz, Rogie Royce Carandang, and Kevin Jace Miranda
374
ARTICLE
Optimization of immediate-release cilostazol tablets using Quality by Design (QbD) approach
by Perlita Crucis, April Mergelle Lapuz, Syrine Faith Diño, Alia Denise Edu, Ralph Gean Francisco, Emmanuel Gutierrez
425
ARTICLE
Determinants of perceived stress and depression among graduating pharmacy students in Metro Manila, Philippines
by Aevonn Balahadia, Mikka Vera Gatdula, Krizza Mhae Diokno, Ferdinand Monterey Jr., Mary Jane Molina, Lizette Angelie Cabreros, Kevin Jace Miranda, Rogie Royce Carandang
455
ARTICLE
PrescripLine: a prototype internet-based platform for the storage of prescription and medication history in telemedicine
by Rosemarie M. Alonte, Justine Ann S. Arenas, Bryce Edison L. Bagas, Miles S. Supendio, Denzel John B. Alonte, Mark Kenneth R. Marcos, and Rogie Royce C. Carandang
484
ARTICLE
The internal and external risk factors related to e-cigarette smoking initiation among selected college participants in a higher education institution in the National Capital Region (NCR), Philippines
by Riana Ashley T. Bautista, Alyssa Anne S. Aboc, Reiko Bridget F. Co, Sean David D. Solomero, Ellaine Grace O. Soneja, Carmelraye P. Sy, Jozelle Denise G. Tuazon, and Julius Eleazar D.C. Jose
491
ARTICLE
Structure, biological, and paralysis mechanism differences between neurotoxins of Clostridium botulinum and Clostridium tetani
by Mary Rose F. Lirio, Ma. Camille Antonette T. Parcon, Zorovabel Joy Quijano, Chanisca Shanne J. Maat, Kyrelle B. Lopez, Justine Jhea C. Ong, Angela Coleen M. Marfal, Adrian Lloyd T. Poncio, and Lanz Jerome J. Piedad
558

FOREWORD
by Juan M. Pulhin
i
ARTICLE
Trichoderma technologies: a complete toolkit for sustainability, resilience, and environmental rehabilitation in Cu-contaminated lowland rice and vegetable areas in Mogpog, Marinduque, Philippines
by Charina Gracia B. Banaay, Marisa R. Luna, Agham C. Cuevas, and Virginia C. Cuevas
1
ARTICLE
Microplastic occurrence in rural and urban surface waters: the cases of Lake Sampaloc and Lake Yambo in San Pablo City, Laguna, Philippines
by Fatima A. Natuel, Damasa B. Magcale-Macandog, Decibel V. Faustino-Eslava, Loucel E. Cui, and Stefan Hotes
10
ARTICLE
Mapping coral reef habitats of Apo Reef Natural Park, Sablayan, Occidental Mindoro, Philippines
by Marion Michael A. Bacabac, Victor S. Ticzon, Jesus Gabriel C. Fetil, and Krystal Dayne T. Villanada
18
ARTICLE
Estimating the recreational benefits of Lake Pandin as a tourism destination in San Pablo City, Laguna, Philippines
by Ma. Grechelle Lyn D. Perez, Damasa M. Macandog, Hildie Maria E. Nacorda, Patricia Ann J. Sanchez, Canesio D. Predo, and Josef Settele
27
ARTICLE
Factors affecting land use and land cover change and fragmentation in selected protected areas in the Philippines
by Anne Frances V. Buhay, Rex Victor O. Cruz, Cristino L. Tiburan Jr., and Juan M. Pulhin
37
ARTICLE
Experiences, Challenges, and Initiatives on Water Resource Management of a Small Island Community: The Case of Basco, Batanes, Philippines
by Jessa O. Aquino,, Patricia Ann J. Sanchez, Unice Faith A. Roa, Maria Helen F. Dayo, Catherine B. Gigantone
49

ARTICLE
On-resin synthesis of the somatostatin venom analog Consomatin Ro1
by Ramoncito Luis B. de Boda, Zildjian G. Acyatan, Gisela P. Concepcion, and Aaron Joseph L. Villaraza
58
ARTICLE
Genomics and metabolomics-based assessment of the biosynthetic potential of the sponge-associated microorganism Streptomyces cacaoi strain R2A-843A from the Philippines
by Zabrina Bernice L. Malto, Joeriggo M. Reyes, Bernard Isaiah D.C. Lo, Kevin Bossie S. Davis, Gisela P. Concepcion, Lilibeth A. Salvador-Reyes
67
ARTICLE
Genistein and daidzein from a sponge-associated fungus (Family: Microstromataceae) show dose and incubation time-dependent Ca2+ influx activity variation
by Miguel Enrique Ma. Azcuna, Zildjian Acyatan, Geminne Manzano, Clairecynth Yu, Porfirio Alexander M. Aliño, Marvin Altamia, Lilibeth Salvador-Reyes, and Gisela P. Concepcion
90
ARTICLE
Genome Mining of a Novel Marine Sponge Symbiont Nocardia sp. BML-15-R-026U Reveals High Biosynthetic Potential for Secondary Metabolites, Including a Non-Ribosomal Peptide and a Polyketide of High Novelty
by Paul Christian T. Gloria, Elaine M. Romines, Marc Jeremie D. Punzalan, Christine Marie C. Florece, Kreighton E. Cadorna, Lilibeth A. Salvador-Reyes, and Arturo O. Lluisma
107

FOREWORD
by Ma. Luisa D. Enriquez
i
ARTICLE
A critique on the “war on drugs” policy in the Philippines
by Leonardo R. Estacio Jr., Laurie S. Ramiro, Hilton Y. Lam, Ma. Esmeralda C. Silva, and Carmencita D. Padilla
1
ARTICLE
A study on complex karyotypes in leukemia by routine G-banding and whole chromosome painting: A report on four Filipino cases
by Ma. Luisa D. Enriquez, Ma. Celeste S. Abad, Michael Ernesto Arnante, and Priscilla B. Caguioa
9
ARTICLE
Knowledge and attitude of Filipino primary caregivers on sugary foods and dental caries among preschool children
by Janelle Kirsten O. Go, and Michael Antonio F. Mendoza
16
ARTICLE
How protected are PhilHealth members and beneficiaries? The 2017 PhilHealth support value survey
by Haidee A. Valverde, Danesto B. Anacio, Abegail L. Garcia, and Hilton Y. Lam
22
ARTICLE
Linguistic validation of Mindfulness Attention Awareness Scale in Filipino
by Jose Ronilo G. Juangco, Jennifer M. Nailes, Joy P. Malinit, and Joey Joline M. Nailes
29
ARTICLE
Measuring the extent of fraudulent-risky benefit claims in PhilHealth
by Allan R. Ulitin, Haidee A. Valverde, Josephine D. Agapito, Kent Jason G. Cheng, Red Thaddeus D. Miguel, Danesto B. Anacio, and Hilton Y. Lam
34
ARTICLE
Chronic arsenic poisoning presenting with widespread bronchiectasis – A case report
by Jeff-Ray T. Francisco, Ruby A. Garcia, Mark Anthony A. Ramos, and Jacqueline T. Ramolete
43
ARTICLE
Soil-transmitted helminthiases in school-age children following more than a decade of control program implementation in Roxas City
by Vicente Y. Belizario, Deanna Lis Pauline F. Cubarrubias, Lunnel Alexie D. Ong, Agnes Q. Villarruz, and Leo C. Biclar
48
ARTICLE
Trans fat policy as pathfinder to curb noncommunicable disease: a review in Philippine perspective
by Ma-Ann M. Zarsuelo, and Zenith D. Zordilla
55

ARTICLE
Characterization of Silver Nanoparticles Produced by Wildtype and Mutants Serratia marcescens Bizio
by Arxel G. Elnar, Andrew D. Montecillo, Leodevico L. Ilag, and Lucille C. Villegas
1
ARTICLE
Detection of enteric viruses in five important tributaries of Laguna Lake, Philippines by PCR assays
by Joy Ann P. Santos, Maribell A. Dollete, Nadine Janelle E. Sinco, Ma. Jowina H. Galarion, Windell L. Rivera
10
ARTICLE
UV-irradiation mutagenesis of Chlorella vulgaris Beijerinck SP17 to enhance lipid production for potential biodiesel application
by Pernelle Pamela M. Bruno, Windell L. Rivera, and Pierangeli G. Vital
16
ARTICLE
Chemical Composition and In vitro Antioxidant and Antibacterial Properties of the Edible Cyanobacterium, Nostoc commune Vaucher
by Milagrosa R. Martinez-Goss, Eldrin DLR. Arguelles, Arsenia B. Sapin, and Ronaniel A. Almeda
25
ARTICLE
Draft genome sequence of a Philippine mangrove soil actinomycete with insecticidal activity reveals potential as a source of other valuable secondary metabolites
by Armi R. Creencia, Edwin P. Alcantara, Maria Genaleen Q. Diaz, Rina B. Opulencia, and Rosario G. Monsalud
36
ARTICLE
Influence of Blastocystis on the Growth of a Representative Gut Bacterium
by Antonio Luis R. Ventura, Davin Edric V. Adao, and John Anthony D. Yason
47

ARTICLE
Synthesis of CdS quantum dots by the acidotolerant fungus Trichoderma asperellum and their potential in the flourescence detection of a leptospirosis-related oligomer
by Kenworth Bryle P. Bal-iyang, Alexia Joanne F. Manuel, Don Joseph F. Rialubin, and Ronan Q. Baculi
1
ARTICLE
The ciprofloxacin resistance of Lactobacillus species isolated from probiotic food products in the Philippines is due to mutations in gyrB and parC genes
by Michael Angelo C. Nicdao, John Clyde Co Soriano, Windell L. Rivera, and Joyce A. Ibana
14
ARTICLE
Endophytic bacteria associated with healthy and rust-infected Coffea arabica L. leaves
by Alysa G. Estopace and Ernelea P. Cao
24
ARTICLE
Phytoplankton composition and diversity in Lake Tikub, Tiaong, Quezon, Philippines
by Nerissa K. Torreta, Jeremaiah L. Estrada, Paul John F. Flores, and Noel G. Sabino
42
ARTICLE
Effects of nutrient depletion on bioethanol production of indigenous Philippine freshwater Chlorella vulgaris SP17
by Katherine L. Pintor, Windell L. Rivera, and Pierangeli G. Vital
50
ARTICLE
A cocktail of Lactobacillus species controls Salmonella infection and maintains animal productivity in poultry farming
by Michael Angelo C. Nicdao
62
ARTICLE
Physico-chemical characterization of a recombinant endoglucanase from a clone derived from a mixed microbial culture from mudspring water of Mt. Makiling, Laguna, Philippines
by Richard D. Tambalo and Asuncion K. Raymundo
72
ARTICLE
Detection of Vibrio parahaemolyticus in fish samples from selected wet markets in Laguna, Philippines, using loop-mediated isothermal amplification (LAMP) and real-time polymerase chain reaction (qPCR)
by Treena Rica D. Teh, Joy Ann P. Santos, Mylene G. Cayetano, and Pierangeli G. Vital
84
ARTICLE
Genotyping of β-Lactamase (blaCTX-M, blaOXA, blaSHV, and blaTEM) genes from Extended-spectrum β-Lactamase-producing Enterobacteriaceae Clinical Isolates of Ospital ng Maynila Memorial Medical Center, Philippines
by Joel C. Cornista, Erika R. de Jesus, Anna Patrizia B. Pacheco, Ramon Arvin Noriel B. Santos, Ronald Cabudoy, and Marilen P. Balolong
92
ARTICLE
Development of a closed-tube QUASR-LAMP assay for the detection of human adenoviruses
by Joy Ann P. Santos and Windell L. Rivera
102
ARTICLE
Streptococcus suis and S. parasuis in the Philippines: Biochemical, molecular, and antimicrobial resistance characterization of the first isolates from local swine
by Susan A. Sedano, Benji Brayan I. Silva, Ani Giliw M. Sangalang, and Merlyn S. Mendioro
107
ARTICLE
Variations in enzymatic activity and response to abiotic factors of endophytic bacteria isolated from Narra (Pterocarpus indicus) growing in a forest environment and urban arboretum
by Liezel D.C. Atole, Margareth Del E. Isagan, Raymond H. Parcon, Virgie A. Alcantara, Jocelyn T. Zarate, and Jessica F. Simbahan
120
ARTICLE
Bacteriophage-based biocontrol of Salmonella enterica ser. Enteritidis in selected ready-to-eat food
by Ramon Arvin Noriel B. Santos and Donna May D. Papa
127
ARTICLE
Archaeal community profiling of a mixed culture from mud and water slurry from a solfataric mudspring as revealed by a community proteome approach
by Andrew D. Montecillo, Leopold L. Ilag, Ajay Kohli, Nacita B. Lantican, and Asuncion K. Raymundo
1
ARTICLE
Cyanobacteria and diatoms in the cyanobacterial mats in a natural salt water hot spring in Coron, Palawan, Philippines
by Milagrosa R. Martinez-Goss, Jean Edward B. Manlapas, and Eldrin DLR Arguelles
11
ARTICLE
Diversity and bioactivities of mangrove fungal endophytes from Leyte and Samar, Philippines
by Carlo Chris S. Apurillo, Lei Cai, and Thomas Edison E. dela Cruz
33
ARTICLE
Bacillus amyloliquefaciens, a Narra (Pterocarpus indicus) leaf endophyte, possesses antifungal activity against phytopathogenic fungi due to laminarinase activity and production of antimicrobial compounds
by Raymond H. Parcon, Margareth Del E. Isagan, Liezel D.C. Atole, Virgie A. Alcantara, and Jessica F. Simbahan
48
ARTICLE
Enhanced in vitro biodegradation of low-density polyethylene using alkaliphilic bacterial consortium supplemented with iron oxide nanoparticles
by Erika Joy G. Cada, Marion Lei C. Muyot, Joanna Maria C. Sison, and Ronan Q. Baculi
55
ARTICLE
Biosorption of nickel by Bacillus cereus and Stenotrophomonas maltophilia isolated from Bayto River, Zambales
by John Rex N. Baldomero and Yolanda A. Ilagan
70
ARTICLE
Alkaline proteases from alkaliphilic and alkalitolerant bacteria from Manleluag Hyperalkaline Spring in Pangasinan, Philippines
by Aryana Lee G. Bertuso, Andrew D. Montecillo, and Nacita B. Lantican
81
ARTICLE
Detection of antimalarial drug resistance markers in Plasmodium falciparum samples from CARAGA, Philippines: a retrospective study
by Maria Lourdes M. Macalinao, Edelwisa Segubre-Mercado, Ronie J. Calugay, Sherwin A. Galit, June Haidee L. Acuna, and
Fe Esperanza J. Espino
91

ARTICLE
Biodegradation of low-density polyethylene by bacteria isolated from serpentinization-driven alkaline spring
by Denisse Yans Z. Dela Torre, Lee A. Delos Santos, Mari Louise C. Reyes and Ronan Q. Baculi
1
ARTICLE
Robust cadmium removal and tolerance by a magnetotactic bacterium isolated from the sediment of an open-pit mine tailings lake
by Ronie J. Calugay, Aurora Ines J. Aguilar, Jerico R. Liwag, Paula S. Ramos, and Ofelia D. Giron
13
ARTICLE
Removal of heavy metals from aqueous solution by biofilm-forming bacteria isolated from mined-out soil in Mogpog, Marinduque, Philippines
by Lucille C. Villegas, Arlene L. Llamado, Kristine V. Catsao, and Asuncion K. Raymundo
18
ARTICLE
Antimicrobial activities of crude culture extracts from mangrove fungal endophytes collected in Luzon Island, Philippines
by Llewelyn S. Moron, Young-Woon Lim, and Thomas Edison E. dela Cruz
28
ARTICLE
Bacteriological screening of fresh and fresh-cut fruits vended in select open air markets and supermarkets in Metro Manila, Philippines
by Adrienne Cornelia Marie Therese A. Mathay, Ma. Angela Z. Dimasupil, Windell L. Rivera, and Pierangeli G. Vital
37
ARTICLE
Determination of the optimal pre-enrichment period for the detection of Salmonella enterica in artificially inoculated meat products using culture, PCR and LAMP assays
by Christine Aubrey C. Justo, Maria Reynalen F. Mapile, Pauline Dianne M. Santos, and Windell L. Rivera
43
ARTICLE
Methicillin-resistant Staphylococcus aureus carriage in a residential care institution for the elderly in Quezon City, Philippines
by Mary Grace B. Ayala, Esperanza C. Cabrera, and Gil M. Penuliar
51
ARTICLE
Prevalence, antibiogram and virulence gene profiles of uropathogenic Escherichia coli from pregnant women with urinary tract infection
by Genevieve L. Serrano and Gil M. Penuliar
59
ARTICLE
Serogroup, pathotype and multiple drug resistance of Escherichia coli strains isolated from the cloaca of layer chickens in San Jose, Batangas, Philippines
by Venice Ann Lorreine M. Bautista and Bernadette C. Mendoza
69
© 2026 SciEnggJ
Philippine-American Academy of Science and Engineering